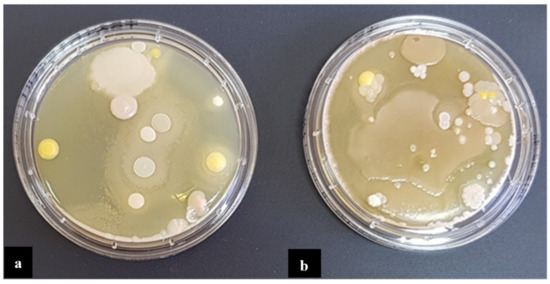

Abstract
The spread of bacterial resistance to antibiotics affects various areas of life. The aim of this study was to assess the occurrence of Pseudomonas aeruginosa, and other bacteria mainly from orders Enterobacterales and Staphylococcus in the pharmaceutical production sites, and to characterize isolated strains in the aspects of antibiotic resistance, biofilm formation, and presence of genes encoding virulence factors. Genes encoding selected virulence factors were detected using PCR techniques. Antimicrobial susceptibility testing was applied in accordance with the EUCAST recommendations. A total of 46 P. aeruginosa strains were isolated and 85% strains showed a strong biofilm-forming ability. The qualitative identification of genes taking part in Quorum Sensing system demonstrated that over 89% of strains contained lasR and rhlI genes. An antimicrobial susceptibility testing revealed nine strains resistant to at least one antibiotic, and two isolates were the metallo-β-lactamase producers. Moreover, the majority of P. aeruginosa strains contained genes encoding various virulence factors. Presence of even low level of pathogenic microorganisms or higher level of opportunistic pathogens and their toxic metabolites might result in the production inefficiency. Therefore, the prevention of microbial contamination, effectiveness of sanitary and hygienic applied protocols, and constant microbiological monitoring of the environment are of great importance.
1. Introduction
Maintaining microbiological purity of the process of manufacturing medicinal products constitute an exceptionally important aspect in pharmaceutical production. The occurrence of bioburden on the surface of production equipment is a serious issue, because of the possibility of microbial contamination of the medicinal products. Any element of the pharmaceutical production environment: raw materials, technological media, personnel, air, or usable surfaces may constitute the source of microorganisms.
The dominant form of microbial existence, both in natural and industrial ecosystems, is biofilm in which microorganisms carry the ability to cause infections. In addition, bacteria in biofilms are more resistant to disinfectants and antibiotics in comparison to their planktonic counterpart [1,2,3]. In order to obtain a medicinal product of adequate microbiological quality, factories manufacturing medications follow the principles of Good Manufacturing Practice (GMP). Maintaining appropriate environmental conditions largely prevent the entry of microorganisms into medicinal products. Otherwise, they could be the cause of iatrogenic infections and cause deterioration of patients’ condition. In addition, the presence of microbes and their metabolites (toxins, enzymes) in medications may cause the loss of medicinal properties of medications due to the degradation of the active or preservative substances. Detection of the presence of pathogenic bacteria or exceeding the permissible quantitative limits in a medicinal product results in the non-release of the defective batch and the production suspension. Because of no legal regulations regarding the microbiological purity of dietary supplements, there is an actual risk of admission of contaminated preparations for sale, posing a threat to patients [4].
Elements of the water system and production equipment are the critical sites favouring colonization by bacteria and biofilm formation in the pharmaceutical production environment. Planktonic cells that break away from the structure of biological membranes can cause contamination of the produced medications, which results in failure to meet the required microbiological quality.
P. aeruginosa is an important human pathogen producing various virulence factors (e.g., exotoxin A, elastaze, protease IV). After entering the human body, bacteria adhere to host cells through adhesive type 4 fimbriae made of pilin protein. Endotoxin-lipopolysaccharide (LPS) constitutes an important factor in the pathogenicity of P. aeruginosa. The most important toxin secreted by P. aeruginosa is exotoxin A, a cytotoxin that has a lethal effect on eukaryotic cells, disrupting protein synthesis. It also affects mitochondria, causing an increase in membrane permeability and damages the electron transport system, thus causing breathing disorders. It plays an important role in the immune response of the host and the development of infection [5].
Proteolytic enzymes secreted by microorganisms play a significant role in the course of sepsis and eye infection due to the degradation of immunoglobulins and fibrin [6]. The presence of numerous virulence factors and formation of biofilm by P. aeruginosa is regulated through the mechanism of “bacteria to bacteria” communication—Quorum Sensing (QS) [2,6,7,8,9].
P. aeruginosa rods are characterized by multiple natural and acquired resistance to antibiotics [5,10,11,12]. An important mechanism of P. aeruginosa resistance is the production of class B metallo-β-lactamase (MBL). MBL positive strains are resistant or have a reduced sensitivity to penicillins, combinations of penicillins with β-lactamase inhibitors (no inhibitor effect), cephalosporins and carbapenems [10,11,12].
Additionally, other microorganisms isolated from the pharmaceutical production environment may have the ability to form biofilms and resistance to antibiotics. This resistance is widespread among clinical and environmental strains [13,14,15].
The aim of this study was to assess the occurrence of P. aeruginosa and other microbiota in the pharmaceutical production environment to characterize isolated strains in the aspects of antibiotic resistance, biofilm formation, and presence of genes encoding virulence factors.
2. Results
2.1. P. aeruginosa Dominated among the Isolated Bacterial Strains
In total, 81 bacterial strains were isolated in the A, B, and C factories, including 60 glucose non-fermenting bacterial rods, 14 strains from the order Enterobacterales and seven Staphylococcus spp. strains. Figure 1 shows growth of bacteria collected from the pharmaceutical production environments in factory A. P. aeruginosa were the most frequently observed in all factories (n = 46). Majority of the strains were isolated from wet areas. Thirty eightwere isolated from sinks, 30 from drains, and 13 from both work and device production surfaces. From the air in production rooms commonly observed microorganisms (such as Bacillus spp. and Micrococcus spp.) were isolated. They were not included in further analyses.
Figure 1.
Bacteria identified on the production equipment (a), and in the air (b), in the pharmaceutical production site A.
2.2. Majority of P. aeruginosa Strains Identified as Strong Biofilm Producers
On the basis of the value of absorbance, in accordance with the biofilm formation criteria all bacteria strains were tested towards their ability to form biofilm and then qualified into appropriate groups in terms of the biofilm forming rate. In total, 68% of all isolates have shown a strong biofilm-forming ability. A total of six strains, including S. saprophyticus, M. luteus, C. freundii and P. stutzeri, were found not to produce any biofilm. The majority of P. aeruginosa strains (n = 39) were found to be strong-biofilm producers (Supplementary Tables S1 and S3). Figure 2 shows microscopic images of the biofilm formed on the PCV and stainless-steel surface. Biofilm formation was clearly observed for all tested strains and surfaces.

Figure 2.
Scanning electron microscopy (SEM) image of biofilm on the PCV (A) and stainless steel (B) surface. Bacteria (1) and water channels (2) are clearly visible and some ‘towers’ (3) as well.
2.3. Genes Involved in the Bacteria Communication and the Virulence Factors Production in P. aeruginosa
The qualitative identification of genes taking part in QS system demonstrated that 89.1% of strains contained lasR gene, while rhlI and rhlR were present in 80.4% of P. aeruginosa isolates (Figure 3, Supplementary Table S2).

Figure 3.
Presence of QS and virulence factors genes in P. aeruginosa (n = 46) strains.
The largest number of strains contained a toxA, gene responsible for production of exotoxin A (97.8%). AprE gene responsible for production of elastase was present in 43 out of 46 (93.4%) tested strains. The least isolates contained a gene responsible for production of protease IV (39.1%) (Figure 3, Supplementary Table S2).
2.4. Correlation of the Ability to Create Biofilms and the Presence of Genes Encoding Virulence Factors and QS
Supplementary Tables S1–S3 contain a summation of results of the qualitative identification of genes taking part in the QS and encoding virulence factors, and a biofilm formation rate in P. aeruginosa strains isolated from the evaluated pharmaceutical environment. A total of nine isolates contained all of the tested genes and were characterized by the strong ability to form biofilm. In total, two strains did not contain any of the identified QS genes, one of tested strains was a moderate producer of biofilm and the other was characterized by poor ability to form biomass. The majority of strains (67.4%) contained all of the tested genes related to QS system and simultaneously were strong biofilm producers. Eleven isolates contained all of the identified genes encoding virulence factors and simultaneously were strong biofilm producers.
2.5. The Pharmaceutical Production Environment Might Be a Source of Antibiotics Resistant Bacteria
A total of nine P. aeruginosa strains out of 46 analysed strains demonstrated resistance to at least one antibiotic. In total, eight strains were resistant to one of the tested aminoglycosides. The largest percentage of sensitive strains was detected towards ciprofloxacin (95.6%) and ticarcillin with clavulanic acid (97.8%). Among beta-lactam antibiotics the largest percentage of resistant strains was detected towards ceftazidime (6.5%) and imipenem (4.3%). Among the order Enterobacterales, 35.7% were tobramycin resistant. In total, 21.4% of strains were resistant to ceftazidime and gentamycin. All strains were sensitive to ciprofloxacin and piperacillin. Figure 4 shows the antibiotic susceptibility test results using the disc diffusion method and detection of MBL with the disc diffusion synergy test. Data of antimicrobial resistance of the tested strains is presented in Table 1.

Figure 4.
Evaluation of antibiotic susceptibility of P. aeruginosa using the disc diffusion method (a) and phenotypic detection of MBL with the disc diffusion synergy test: positive (b), and negative (c). Enhancement of the zone of inhibition in the area between imipenem/EDTA and ceftazidime/EDTA disks was interpreted as a positive result for MBL production.

Table 1.
Antimicrobial resistance among tested strains.
Tests detecting carbapenemases formation were carried out for strains that turned out to be resistant or intermediate to imipenem and/or meropenem. Two isolates of the following turned out to be producers of metallo-beta-lactamases MBL; no strain was a producer of carbapenemases KPC. In the aspect of places of P. aeruginosa strains isolation, it was found that strains resistant to the tested antibiotics were isolated from the aquatic environments. The largest number of strains resistant to at least one antibiotic were isolated from sinks. Additionally, strains that turned out to be MBL producers were isolated from the aquatic environments. One strain was a producer of the extended spectrum β-lactamase.
Out of 46 P. aeruginosa strains, six isolates (13.0%) resistant to gentamicin, three isolates (6.5%) resistant to ceftazidime, three isolates (6.5%) resistant to tobramycin, two isolates (4.3%) resistant to imipenem and one (2.2%) resistant to ticarcilin/clavulanate, meropenem and ciprofloxacin were observed. Among strains from the order Enterobacterales five (35.7%) were resistant to tobramycin, three (21.4%) were resistant to ceftazidime and gentamicin, and one (7.1%) to ticarcilin/clavulanate. There were no observed resistance to cefoxitin, erythromycin and clindamycin among the Staphylococcus spp. strains.
3. Discussion
Medicines and dietary supplements may be contaminated by wide spectrum of microbes. Medicines must meet the microbiological purity criteria in accordance with applicable legal regulations [16].
The European Medicines Agency (EMA) is the European institution that supervises the quality of medicines and ensures public health safety in the European Union. The agency, among others, is responsible for the coordinating of withdrawals actions of the drug, which that do not meet the requirements, across the EU. In 2018, the agency received 147 suspected quality defect notifications. Of these, 123 cases were confirmed quality defects and led to batch recalls of 27 centrally authorized medicines. Among these products, 5 were withdrawn from the market due to microbial contamination [17]. A much larger number of drugs that do not meet the requirements for microbiological purity are withdrawn in the USA than in Europe. FDA withdrew 74 products from the market due to microbiological contamination in 2018, and from 1 January 2019 to 21 June 2019 as many as 459 products. The main reasons for the recall of the drugs were being out of specification for mould, yeast and bacteria, and were being found to contain microbial contaminants S. aureus, S. saprofhyticus and Burgholderia cepatia, Burgholderia multivorans, P. aeruginosa, P. brenneri, P. fluroescens, Paecilomyces saturates and Aspergillus fumigatus [18].
Jimenez L. found that FDA product recall data for 134 non-sterile pharmaceutical products demonstrated that 48% of recalls were due to contamination by either B. cepacia, Pseudomonas spp., or Ralstonia picketti, while yeast and mould contamination were found in 23% of recalls. Gram-negative bacteria accounted for 60% of recalls, but only 4% were associated with Gram-positive bacteria [19].
In our previous research, the microbiological contamination that exceeded the limit was found in 1.3% of medicines and 14.3% dietary supplements. The products were mainly contaminated by Enterobacterales. None of the samples was found to contain bacteria with a higher disease-causing potential such as, for example, Salmonella spp. The presence of bacteria from the order Enterobacterales, chiefly E. coli, points to contamination of fecal origin and may indicate that the hygienic conditions in the manufacturing plant were inadequate. The performed microbiological control of the completed pharmaceutical products have prevented the release of contaminated product series for sale [16].
A persistent level of product recall for microbial contamination highlights the risk for quality of drugs and for health and life of patients. Contaminated with microbes, pharmaceutical products may be the cause of drug-induced infections. In 2004, a large outbreak of catheter-associated Gram-negative BSIs among patients in an oncology chemotherapy centre was recorded with the 27 confirmed positive blood cultures cases: 20 for E. cloacae, 2 for K. oxytoca, 5 for both. The reason for this outbreak was the injection of the isotonic sodium chloride solution contaminated with K. oxytoca, E. cloacae, through the central venous catheters of patients [20,21].
Raw materials, pharmaceutical production environment and personnel are the sources of microbial contaminations. Previously, analysing biological contamination of humid pharmaceutical production environments, such as sink traps or sewage grates, it was found that in 26% of tested samples Gram-negative rods of Pseudomonas, Stenotrophomonas, Acinetobacter, Aeromonas, and rods from the order Enterobacterales were identified. Pseudomonas spp. were the most frequently isolated and the dominant species were Pseudomonas aeruginosa [22].
In 2018, the North Carolina–based King Bio Inc. recalled from the market all of its water-based products for human and animal use due to high levels of microbial contamination. Several microbial contaminants were found in products, including P. brenneri, P. fluorescens and B. multivorans—microbes that can cause illness in people with compromised immune systems. What is more, evidence collected during the FDA’s inspection indicated recurring microbial contamination associated with the water system used to manufacture drug products [23].
Tršan et al., reported a catalogue of cleanroom microorganisms isolated from four different cleanrooms which indicated that 78% of isolated bacteria were Gram-positive and majority of the species (>70%) were belonging to the normal human microbiota. The microorganisms were derived from the air (10–15%, Bacillus spp., fungi) and water (5–10%, Gram-negative microorganisms). Additionally, in our study, most strains were isolated from wet areas. Non-fermenting rods and bacteria from the order Enterobacterales were dominant. The source of Gram-negative microorganisms in the pharmaceutical production environment are usually water systems [24].
The fact that bacteria form biological membranes poses a serious problem for the health care system, and both food production and pharmaceutical industry [10,25,26,27]. We demonstrated that 100% of P. aeruginosa strains isolated from the pharmaceutical production environment were able to form biofilm with the greatest number of stains displaying high degree of biofilm formation. In accordance with the previously published data, Marchand et al., provided evidence that the P. aeruginosa strain, which formed biofilm in a food environment, communicated with other bacteria e.g., with Listeria monocytogenes, forming a multi-species biofilm [28]. Additionally, it is believed that 80–100% of the strains isolated from clinical infections are capable of forming biofilm [29,30]. In our study, after analysing the location of those bacteria that displayed high degree of biofilm formation, it has been observed that most of the isolates originated from sinks and drains. Humid sites in the pharmaceutical production environment are critical sites that promote the formation of biofilms.
Bacteria cells from the Pseudomonas genus have two QS systems. The las system which involves lasR and lasI gene and the rhl system which involves of rhlR and rhlI genes [31]. Here we observed that only three isolates of P. aeruginosa did not contain any of the analysed genes. On the other hand, most of them contained all of the assessed QS genes. Similar results have been reported on the strains of P. aeruginosa, isolated from respiratory tract infections, showing that 68.7% of isolates contained all four genes; 18.7% of the strains, on the other hand, did not contain any of the analysed genes [32]. In another report on strains from different clinical materials, 81.6% of the isolates contained at least one of the analysed genes [33].
While comparing the content of genes responsible for QS in tested P. aeruginosa strains and the capability of these isolates to form biofilms, we observed that almost all of them were characterized with high capability to form biofilm. On the other side, among the strains which did not contain any of the QS genes, two isolates formed biofilm to a moderate extent, and one displayed a poor capability of forming biological membrane.
Here, we have focused on several of virulence factors produced by P. aeruginosa strains. Here, the presence of the gene responsible for production of elastase has been observed in majority of examined strains. Alkaline protease enables growth of bacteria in the organism of an infected host and influence its immune system. In our study, in more than half of the analysed environmental strains, a gene determining production of alkaline protease was found. The lysyl, gene encoding peptidase IV was also present in the tested P. aeruginosa strains. Our results of the identification of the toxA gene, responsible for production of exotoxin A, seem to resemble the previously published data [31,34].
According to our research results, P. aeruginosa strains isolated from the pharmaceutical production environment have contained genes responsible for the production of virulence factors in very similar proportions comparing to strains isolated from infections [30,31].
Our evaluation concerning the drug susceptibility of the P. aeruginosa and Enterobacterales strains isolated from the environment of pharmaceutical production indicated that 6.5% of the P. aeruginosa strains were resistant to ceftazidime. Among the tested P. aeruginosa strains, there was one resistant and one with medium resistance to ciprofloxacin. More strains displayed resistance to gentamicin (13.0%) and tobramycin (6.5%). Moreover, it was demonstrated that environmental strains may display resistance to carbapenems. Among the analysed strains, one displayed resistance and one intermediate to meropenem. Similarly, in the in case of imipenem, two strains were resistant and one intermediate. One strain was resistant to both carbapenems and other antibiotics tested. Frequency of Gram-negative bacteria’s resistance to carbapenems has been increasing all over the world. Acquisition of MBL-coding genes is considered one of the most significant carbapenems resistance mechanisms [10,35,36,37]. We found that two strains (4.3%) were MBL positive. One strain that was isolated from the production facility sink, was resistant to all the tested antibiotics; additionally, this bacterium was characterized by additional MBL resistance mechanism. Another strain, in which metallo-β-lactamase formation was observed, was isolated from a floor drain.
Enterobacterales strains were also found here to be resistant to antibiotics. Among the tested strains, resistance to tobramycin, ceftazidime and gentamycin were observed. All strains were sensitive to ciprofloxacin and piperacillin. Moreover, one strain produced extended spectrum β-lactamase.
We observed that strains isolated from the pharmaceutical production environment were far less resistant to antibiotics than the strains isolated from clinical materials. According to the research carried out in 36 countries (Latin America, Asia, Africa and Europe) by the International Nosocomial Infection Control Consortium (INICC), 47.2% of P. aeruginosa strains isolated from infections were resistant to imipenem [20]. Tests done on strains isolated from patients hospitalized due to pneumonia in the Unites States and Europe showed that, respectively, 23.7 and 34.2% of strains were resistant to meropenem.
Summarizing, the bacterial strains isolated at the manufacturing premises have the ability to produce biofilm, which leads to problems with microbiota eradication. Moreover, the majority of P. aeruginosa strains isolated from the pharmaceutical production environment was characterized by the presence of genes encoding various virulence factors. This study identified P. aeruginosa strains exhibiting resistance to routinely used antibiotics in the pharmaceutical environment. Therefore, the results demonstrated that the pharmaceutical production environment is a source of potentially pathogenic microorganisms which might contaminate drugs manufactured on the premises. The prevention of microbial contamination, and adequate manufacturing and storage conditions are of great importance. The environment of pharmaceutical production and the effectiveness of sanitary and hygienic methods should be persistently monitored to reduce contamination of medicinal products and eliminate sources of potentially pathogenic microorganisms.
4. Material and Methods
Microbiological purity of the pharmaceutical production environment in three different drug factories, that have EU GMP accreditation, localized in Poland was assessed. These factories produce non-sterile and finished dosage forms of drugs. Samples were collected during batch production as part of the previously implemented sanitary and hygienic procedures. Smears were taken from the production devices, work surfaces, sinks, and drains in the production rooms. Bacterial strains were isolated from the taken smears and underwent further tests. The microbiological purity of the air was investigated using the impact method in accordance with GMP [38]. In addition, numerous medicinal products manufactured in those pharmaceutical production environments were assessed in accordance with the European Pharmacopoeia 9.0 [39].
4.1. Isolation of Bacteria Strains
Samples were collected from the tested surfaces (25 cm2), inside of a tap, drain traps and drain gratings using sterile swabs moistened in a sterile NaCl solution and/or using contact plates (Oxoid, Wesel, Germany). Identification to the level of genus was possible based on microscopic and macroscopic assessment of bacterial colonies as well as biochemical tests: ID Color Catalase (BioMérieux, Marcy-l’Étoile, France)—the reagent detects the presence of catalase, thus enabling the differentiation of bacteria that possess this characteristic, Bactident Oxidase test (MERCK, Darmstadt, Germany)—for the detection of cytochrome oxidase in microorganisms. Identification of the isolated strains to the level of species was carried out using an automatic identification system VITEK® Compact 2 (BioMérieux, Durham, NC, U.S.). GN cards (BioMérieux, Durham, NC, U.S.) were used for identification of Enterobacterales and a select group of nonfermenting Gram-negative organisms, GP cards (BioMérieux, Durham, NC, U.S.) were applied for the identification of enterococci, streptococci, staphylococci and a selected group of gram-positive organisms. All identified strains were stored for further tests in temperature −80 ± 10 °C, in microbanks (Pro-Lab Diagnostics, Richmond Hill, ON, Canada).
4.2. Quantitative Assessment of Biofilm Formation in Vitro
Biofilm formation was determined by the microtiter plate assay, as previously reported [40]. Briefly, three wells of 96-well flat-bottomed plastic plate were filled with 200 µL of each tested bacterial suspension. The plates were covered and incubated aerobically for 24 h at 37 °C. Then, the content of each well was aspirated, and each well was washed three times with 250 µL of sterile physiological saline. Then, plates were stained for 15 min with 0.2 mL. of 2% crystal violet. Then, each well was washed with physiological saline solution. After the plates were air dried, 200 µL of 99% methanol per well were added, absorbance of each well was measured at 590 nm, using the Infinite M200 (Tecan, Grödig, Austria). Simultaneous biofilm formation assay on the PCV and stainless steel surface was carried. Biofilm was grown using PCV and stainless steel discs. The discs inoculated with bacterial suspension in BHI were incubated at 36 °C for 48 h. After incubation, the medium was removed, and the discs were gently washed twice with distillated water dehydrated and fixed in increasing concentrations of ethanol. Scanning electron microscopy (SEM) was used to illustrate the study results.
4.3. Identification of Genes Taking Part in QS and Encoding Virulence Factors in P. aeruginosa Strains
DNA extraction from the isolated P. aeruginosa strains was carried out using the in house developed thermal extraction method and the obtained DNA was stored for further analysis in temperature −20 ± 2 °C.
For the qualitative assessment of genes encoding virulence factors and taking part in QS eight PCR reaction starters designed using the Primer3 programme (available at http://bioinfo.ut.ee/primer3-0.4.0) and checked in terms of appropriate parameters using Primer-BLAST function (Basic Local Alignment Search Tool) available in an online base NCBI (National Center for Biotechnology Information) were used. The primers for the tested genes (lasI, lasR, rhlI, rhlR, aprE, lasB, lysyl, toxA) were designed based on the P. aeruginosa PAO1 genomic sequence PAO1nr Ac. Num. NC_002516.2. Supplementary Table S4 presents the applied starters and PCR conditions applied (Supplementary Table S4 and Supplementary 2). The presence or absence of amplified fragments of taking part in QS (lasI, lasR, rhlI, rhlR) and the virulence factors (aprE, lasB, lysyl, toxA) gene sequences were analysed.
4.4. Evaluation of Antibiotic Susceptibility of the Isolated Bacterial Strains
Assessment of antibiotics susceptibility of P. aeruginosa and other isolated bacterial strains was carried out using the disc diffusion method in accordance with the EUCAST recommendations [41]. Gentamicin 10 µg, ciprofloxacin 5 µg, ceftazidime 10 µg, tobramycin 10 µg, ticarcillin with clavulanic acid 75/10 µg, imipenem 10 µg, and meropenem 10 µg were used to test the drug susceptibility for P. aeruginosa (Figure 2). For the order Enterobacterales, gentamicin 10 µg, ciprofloxacin 5 µg, ceftazidime 10 µg, tobramycin 10 µg and piperacillin 30 µg were used. Erythromycin 15 µg, clindamycin 2 µg and cefoxitin 30 µg were examined in staphylococci.
4.5. Detection of Mechanisms of Resistance to Antibiotics
Carba NP test and phenotypic screening test with EDTA for metallo-beta-lactamases (MBL) as well as a test with boronic acid for carbapenemases (KPC) were carried out to detect the medium sensitive non-fermenting strains or resistant to carbapenemases and resistant to ticarcillin with clavulanic acid non-fermenting strains.
For all isolates of Enterobacterales, an extended-spectrum beta-lactamases (ESBL) using a double-disc synergy test were assessed. Staphylococcus spp. resistance to methicillin was determined using the disc with cefoxitin 30 µg.
Supplementary Materials
The following are available online at https://www.mdpi.com/2076-0817/10/2/130/s1, Supplementary 1, Table S1: The qualitative identification of genes taking part in the Quorum Sensing (QS), genes encoding virulence factors, and biofilm formation rate in Pseudomonas aeruginosa strains isolated from the pharmaceutical environment. Results for the particular isolated strains. Table S2: The qualitative identification of genes taking part in the Quorum Sensing (QS), genes encoding virulence factors, and biofilm formation rate in Pseudomonas aeruginosa strains isolated from the pharmaceutical environment. Summation of the experimental observations concerning the presence of QS and virulence factors genes Table S3: The qualitative identification of genes taking part in the Quorum Sensing (QS), genes encoding virulence factors, and biofilm formation rate in Pseudomonas aeruginosa strains isolated from the pharmaceutical environment. Summation of the experimental observations concerning the ability to form biofilm by tested strains. Table S4: PCR detection of tested genes. Oligonucleotide sequences for identification of genes taking part in Quorum Sensing and genes encoding virulence factors in P. aeruginosa strains. Supplementary 2: PCR reaction conditions.
Author Contributions
Conceptualization, M.R. and M.G.; methodology, M.R., D.K. and J.D.; validation, M.R., D.K. and J.D.; formal analysis, M.R., D.K., J.D. and M.G.; investigation, M.R., D.K. and J.D.; data curation, M.R., D.K. and J.D.; writing—original draft preparation, M.R., D.K. and J.D.; writing—review and editing, M.G.; funding acquisition, M.G. All authors have read and agreed to the published version of the manuscript.
Funding
This work was supported, in part, by the Poznan University of Medical Sciences, grant no. 502-14-03301402-09911.
Institutional Review Board Statement
Not applicable.
Informed Consent Statement
Not applicable.
Data Availability Statement
Not applicable.
Conflicts of Interest
The authors declare no conflict of interest.
References
- Stewart, P.S.; Franklin, M.J. Physiological heterogeneity in biofilms. Nat. Rev. Microbiol. 2008, 6, 199–210. [Google Scholar] [CrossRef] [PubMed]
- Wang, Y.; Gao, L.; Rao, X.; Wang, J.; Yu, H.; Jiang, J.; Zhou, W.; Wang, J.; Xiao, Y.; Li, M.; et al. Characterization of lasR-deficient clinical isolates of Pseudomonas aeruginosa. Sci. Rep. 2018, 8, 13344. [Google Scholar] [CrossRef] [PubMed]
- Chang, Y.; Wang, P.-C.; Ma, H.-M.; Chen, S.-Y.; Fu, Y.-H.; Liu, Y.-Y.; Wang, X.; Yu, G.-C.; Huang, T.; Hibbs, D.E.; et al. Design, synthesis and evaluation of halogenated furanone derivatives as quorum sensing inhibitors in Pseudomonas aeruginosa. Eur. J. Pharm. Sci. 2019, 140, 105058. [Google Scholar] [CrossRef] [PubMed]
- Georgi, U.; Lämmel, J.; Datzmann, T.; Schmitt, J.; Decker, S. Do drug-related safety warnings have the expected impact on drug therapy? A systematic review. Pharmacoepidemiol. Drug Saf. 2020, 29, 229–251. [Google Scholar] [CrossRef]
- Ochoa, S.A.; Cruz-Córdova, A.; Rodea, G.E.; Cazares-Dominguez, V.; Escalona, G.; Arellano-Galindo, J.; Hernandez-Castro, R.; Reyes-Lopez, A.; Xicohtencatl-Corteees, J. Phenotypic characterization of multidrug-resistant Pseudomonas aeruginosa strains isolated from pediatric patients associated to biofilm formation. Microbiol. Res. 2015, 172, 68–78. [Google Scholar] [CrossRef] [PubMed]
- Andrejko, M.; Zdybicka-Barabas, A.; Janczarek, M.; Cytryńska, M. Three Pseudomonas aeruginosa strains with different protease profiles. Acta Biochim. Pol. 2013, 60, 83–90. [Google Scholar] [CrossRef]
- Khan, F.; Manivasagan, P.; Pham, D.T.N.; Oh, J.; Kim, S.K.; Kim, Y.M. Antibiofilm and antivirulence properties of chitosan-polypyrrole nanocomposites to Pseudomonas aeruginosa. Microb. Pathog. 2019, 128, 363–373. [Google Scholar] [CrossRef]
- Saleh, M.M.; Abbas, H.A.; Askoura, M.M. Repositioning secnidazole as a novel virulence factors attenuating agent in Pseudomonas aeruginosa. Microb. Pathog. 2019, 127, 31–38. [Google Scholar] [CrossRef]
- Vandeplassche, E.; Sass, A.; Lemarcq, A.; Dandekar, A.A.; Coenye, T.; Crabbé, A. In vitro evolution of Pseudomonas aeruginosa AA2 biofilms in the presence of cystic fibrosis lung microbiome members. Sci. Rep. 2019, 9, 12859. [Google Scholar] [CrossRef]
- Samira, H.; Fereshteh, E. Biofilm formation and β-Lactamase production in Burn isolates of Pseudomonas aeruginosa. Jundishapur J. Microbiol. 2015, 8, 15514. [Google Scholar] [CrossRef]
- Cipolla, D.; Blanchard, J.; Gonda, I. Development of Liposomal Ciprofloxacin to Treat Lung Infections. Pharmaceutics 2016, 8, 6. [Google Scholar] [CrossRef] [PubMed]
- Abbara, S.; Pitsch, A.; Jochmans, S.; Hodjat, K.; Cherrier, P.; Monchi, M.; Vinsonneau, C.; Diamantis, S. Impact of a multimodal strategy combining a new standard of care and restriction of carbapenems, fluoroquinolones and cephalosporins on antibiotic consumption and resistance of Pseudomonas aeruginosa in a French intensive care unit. Int. J. Antimicrob. Agents 2019, 53, 416–422. [Google Scholar] [CrossRef] [PubMed]
- Somboro, A.M.; Sekyere, O.J.; Amoako, D.G.; Essack, S.Y.; Bester, L.A. Diversity and Proliferation of Metallo-β-Lactamases: A Clarion Call for Clinically Effective Metallo-β-Lactamase Inhibitors. Appl. Environ. Microbiol. 2018, 84, e00698-18. [Google Scholar] [CrossRef] [PubMed]
- Masadeh, M.M.; Alzoubi, K.H.; Ahmed, W.S.; Magaji, A.S. In Vitro Comparison of Antibacterial and Antibiofilm Activities of Selected Fluoroquinolones against Pseudomonas aeruginosa and Methicillin-Resistant Staphylococcus aureus. Pathogens 2019, 8, 12. [Google Scholar] [CrossRef] [PubMed]
- European Centre for Disease Prevention and Control. Available online: https://www.ecdc.europa.eu/en (accessed on 16 April 2020).
- Długaszewska, J.; Ratajczak, M.; Kamińska, D.; Gajecka, M. Are dietary supplements containing plant-derived ingredients safe microbiologically? Saudi Pharm. J. 2019, 27, 240–245. [Google Scholar] [CrossRef]
- EMA Annual Report 2018 Published. Available online: https://www.ema.europa.eu/en/news/ema-annual-report-2018-published (accessed on 12 April 2020).
- Enforcement Reports. Available online: https://www.fda.gov/safety/recalls-market-withdrawals-safetyalerts/enforcement-reports (accessed on 7 May 2020).
- Jimenez, L. Microbial diversity in pharmaceutical product recalls and environments. PDA J. Pharm. Sci. Technol. 2007, 61, 383–399. [Google Scholar]
- Tresoldi, A.T.; Padoveze, M.C.; Trabasso, P.; Veiga, J.F.S.; Marba, S.T.M.; Nowakonski, A.; Moretti Branchini, M.L. Enterobacter cloacae sepsis outbreak in a newborn unit caused by contaminated total parenteral nutrition solution. Am. J. Infect. Control. 2002, 8, 258–261. [Google Scholar] [CrossRef]
- Watson, J.T.; Roderick, C.; Jones, A.M.; Siston, J.R.; Fernandez, K.M.; Beck, E.; Sokalski, S.; Bette, J.; Matthew, J.; Srinivasan, A.; et al. Outbreak of Catheter-Associated Klebsiella oxytoca and Enterobacter cloacae Bloodstream Infections in an Oncology Chemotherapy Center. Arch. Intern. Med. 2005, 165, 2639–2643. [Google Scholar] [CrossRef]
- Długaszewska, J.; Muszyński, Z. Biological purity of the medicinal product manufacturing environment. Farm. Pol. 2009, 65, 323–326. [Google Scholar]
- Dozens of Drug Products Recalled due to Microbial Contamination. Available online: https://www.pharmacytimes.com/resource-centers/veterinary-pharmacy/dozens-of-drug-products-recalled-due-to-microbial-contamination (accessed on 24 April 2020).
- Tršan, M.; Seme, K.; Srčič, S. The environmental monitoring in hospital pharmacy cleanroom and microbiota catalogue preparation. Saudi Pharm. J. 2019, 27, 455–462. [Google Scholar] [CrossRef]
- Karatuna, O.; Yagci, A. Analysis of quorum sensing-dependent virulence factor production and its relationship with antimicrobial susceptibility in Pseudomonas aeruginosa respiratory isolates. Clin. Microbiol. Infect. 2010, 16, 1770–1775. [Google Scholar] [CrossRef] [PubMed]
- Flemming, H.C.; Wingender, J. The biofilm matrix. Rev. Microbiol. 2012, 8, 623–633. [Google Scholar] [CrossRef] [PubMed]
- Claessen, D.; Rozen, D.E.; Kuipers, O.P.; Sogaard-Andersen, L.; Van Wezel, G.P. Bacterial solutions to multicellularity: A tale of biofilms, filaments and fruiting bodies. Nat. Rev. Microbiol. 2014, 12, 115–124. [Google Scholar] [CrossRef] [PubMed]
- Marchand, S.; De Block, J.; De Jonghe, V.; Coorevits, A.; Heyndrickx, M.; Herman, L. Biofilm formation in milk production and processing environments; influence on milk quality and safety. Compr Rev. Food Sci. Food Saf. 2012, 11, 133–147. [Google Scholar] [CrossRef]
- Harmsen, M.; Yang, L.; Pamp, S.J.; Tolker-Nielsen, T. An update on Pseudomonas aeruginosa biofilm formation, tolerance, and dispersal. FEMS Immunol. Med. Microbiol. 2012, 59, 253–268. [Google Scholar] [CrossRef] [PubMed]
- Kadhim, D.; Ali, M.R. Prevalence study of quorum sensing groups among clinical isolates of Pseudomonas aeruginosa. Int. Curr. Microbiol. Appl. Sci. 2014, 3, 204–2015. [Google Scholar]
- Senturk, S.; Ulusoy, S.; Bosgelmez-Tinaz, G.; Yagci, A. Quorum sensing and virulence of Pseudomonas aeruginosa during urinary tract infections. J. Infect. Dev. Ctries 2012, 6, 501–507. [Google Scholar] [CrossRef]
- Wolska, K.; Szweda, P. Genetic features of clinical P. aeruginosa strains. Polish J. Microbiol. 2009, 58, 255–260. [Google Scholar]
- Mittal, R.; Sharma, S.; Chhibber, S.; Harjai, K. Contribution of quorum-sensing systems to virulence of Pseudomonas aeruginosa in an experimental pyelonephritis model. J. Microbiol. Immunol. Infect. 2006, 39, 302–309. [Google Scholar]
- Sabharwal, N.; Dhall, S.; Chhibber, S.; Harjai, K. Molecular detection of virulence genes as markers in Pseudomonas aeruginosa isolated from urinary tract infections. Int. Mol. Epidemiol. Genet. 2014, 5, 125–134. [Google Scholar]
- Cornaglia, G.; Giamarellouu, H.; Rossolini, G.M. Metallo-β-lactamases: A last frontier for β-lactams? Lancet Infect. Dis. 2011, 11, 381–393. [Google Scholar] [CrossRef]
- Demirdjian, S.; Sanchez, H.; Hopkins, D.; Berwin, B. Motility-Independent Formation of Antibiotic-Tolerant Pseudomonas aeruginosa Aggregates. Appl. Environ. Microbiol. 2019, 85, e00844-19. [Google Scholar] [CrossRef]
- Commission Directive (UE) 2017/1572 of 15 September 2017, Supplementing Directive 2001/83/EC of the European Parliament and of the Council as Regards the Principles and Guidelines of Good Manufacturing Practice for Medicinal Products for Human Use. Available online: https://eur-lex.europa.eu/eli/dir/2017/1572/oj (accessed on 18 June 2020).
- Sanganyado, E.; Gwenzi, W. Antibiotic resistasnce in drinking water systems: Occurrence, removal, and human health risks. Sci. Total Environ. 2019, 669, 785–797. [Google Scholar] [CrossRef] [PubMed]
- EDQM. Methods of Analysis. In European Pharmacopoeia; European Directorate for the Quality of Medicines & Health Care (EDQM): Strasbourg, France, 2016; pp. 195–234, 579–580. [Google Scholar]
- Długaszewska, J.; Antczak, M.; Kaczmarek, I.; Jankowiak, R.; Buszkiewicz, M.; Herkowiak, M.; Michalak, K.; Kukuła, H.; Ratajczak, M. In vitro biofilm formation and antibiotic susceptibility of Pseudomonas aeruginosa isolated from airways of patient with cystic fibrosis. J. Med. Sci. 2016, 85, 245–253. [Google Scholar] [CrossRef][Green Version]
- European Committee on Antimicrobial Susceptibility Testing Breakpoint Tables for Interpretation of MICs and Zone Diameters. Version 8.1. Available online: http://www.eucast.org (accessed on 21 January 2020).
Publisher’s Note: MDPI stays neutral with regard to jurisdictional claims in published maps and institutional affiliations. |
© 2021 by the authors. Licensee MDPI, Basel, Switzerland. This article is an open access article distributed under the terms and conditions of the Creative Commons Attribution (CC BY) license (http://creativecommons.org/licenses/by/4.0/).